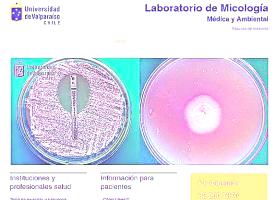

Más leídas
Actualidad | Pág. 4
Codelco pide que declaren

Clasificados | Pág. 18
Laboratorios UV
Chile | Pág. 13
Diputados de Chile Vamos repudian visita del juez español Baltasar Garzón

Chile | Pág. 15
Al menos 22 fallecidos y más de mil heridos deja un terremoto en Turquía

Chile | Pág. 15
China suspende lo viajes hacia y desde Beijing para evitar contagios
Espectáculos | Pág. 16
Rosalía y Billie Eilish, entre las favoritas a los Grammy

Espectáculos | Pág. 16
"Tacto" y "Chocadito": los dos nuevos discos que prepara Ases Falsos
Espectáculos | Pág. 16
¿Dónde se ven?

Clasificados | Pág. 18
CIB-UV

Clasificados | Pág. 18
Enfermedades por alimentos: ¡cuidado con lo que comes!
Cartelera y Tv | Pág. 19
Raúl Mavrakis Morales

Chile | Pág. 12
Detectan listeria en salmón ahumado de una marca y ordenan retiro de lotes
Deportes | Pág. 21
El Derby de la hípica nacional ya entra en la recta final

Deportes | Pág. 21
En Everton sacan cuentas alegres
Deportes | Pág. 21
Joao Souza es suspendido de por vida por amaño de partidos

Deportes | Pág. 21
Zaguero Eric Ahumada se suma mañana a las prácticas de Cobreloa

Deportes | Pág. 22
Juegos del Mar 2020 inició con éxito en el borde costero

Deportes | Pág. 22
"Pumas" iniciaron con victoria el torneo, pero con dudas en el juego

Deportes | Pág. 23
Con un Vidal que ingresó en el segundo tiempo, el Barça no pudo frente al Valencia

Deportes | Pág. 23
Hoy
Chile | Pág. 12
Plebiscito: RN anuncia libertad de acción y apoya a su presidente Mario Desbordes

Chile | Pág. 10
PSU: informan locales de rendición para los más de 111 mil postulantes

Actualidad | Pág. 4
Dirigentes de Chuquicamata van al Congreso por supuestos sobreprecios en seguros de vida

Actualidad | Pág. 7
En caso de Alerta Roja personas en situación de calle serán asistidas

Reportaje | Pág. 4
El día que Armando Uribe por fin bailó con Cecilia

Actualidad | Pág. 5
Adelantan la campaña de vacunación contra la influenza por brote más agresivo en 10 años

Actualidad | Pág. 5
Aprueban $229 millones para adquirir tres ambulancias para San Pedro de Atacama
Reportaje | Pág. 6
Ibrahim Ferrer

Actualidad | Pág. 6
Atacan vehículo policial y carabineros sufren heridas y quemaduras

Actualidad | Pág. 6
Delincuentes armados logran robar camioneta desde pasaje

Actualidad | Pág. 6
Docentes se capacitaron en patrimonio y medio ambiente

Reportaje | Pág. 6
La muerte no discrimina

Actualidad | Pág. 7
Entregan forraje e inician trabajos con maquinaria en pueblo de Turi

Chile | Pág. 10
Ministro Walker: "Debemos ir a buscar nuevas fuentes de agua, que las tenemos"

Reportaje | Pág. 8
En resumen

Opinión | Pág. 8
La urgente necesidad de reducir las emisiones
Opinión | Pág. 8
Resguardos para rendir la PSU

Opinión | Pág. 8
"Mi casa será llamada casa de oración"

Reportaje | Pág. 8
"El escándalo", llega la película clave del "Me too"
Opinión | Pág. 9
En Twitter: #coronavirus
Opinión | Pág. 9
Nuestro archivo
Opinión | Pág. 9
Correo

Deportes | Pág. 23
Lorenzetti firma como refuerzo de Iquique